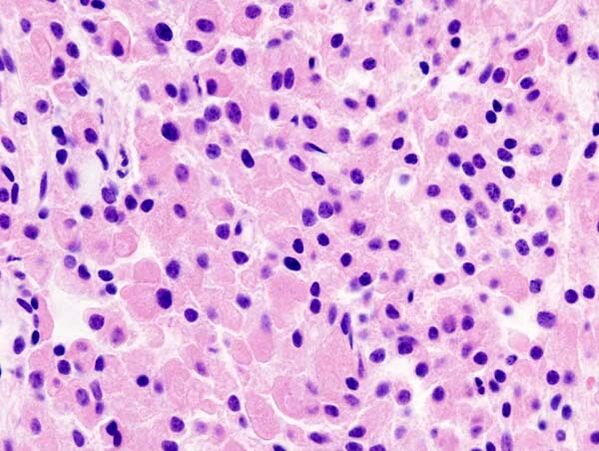

Аденома гипофиза
Адено́ма гипо́физа — опухоль железистой ткани гипофиза (развиваются из передней доли — аденогипофиза)[1].
Общие сведения
Этиология
В большинстве случаев причина остаётся неустановленной. Определённое значение отводится последствиям черепно-мозговых травм, нейроинфекции, интоксикации, патологии беременности и родов, применению оральных контрацептивов[1].
Аденома гипофиза занимает лидирующую позицию из всех опухолевых заболеваний железы. Наиболее часто появляется аденома гипофиза у взрослых, но порой встречается и у детей, хотя и намного реже. Пик заболеваемости наблюдается у людей от 30 до 50 лет. Мужчины и женщины болеют с одинаковой частотой. На аденому гипофиза приходится шестая часть всех опухолей головного мозга. Очень часто опухоль протекает бессимптомно, поэтому выявляемость на 100 тыс. населения составляет всего 2 человека. Именно поэтому часто требуется операция по удалению аденомы, так как медикаментозные средства уже неэффективны.
Патогенез
Процесс развития новообразования проходит несколько этапов. На каждом из этапов последовательно включаются определённые патогенетические механизмы. К примеру, генетические, аутокринные, гормональные, паракринные. Большую роль в патогенезе играют гипоталамические гормоны, а также факторы роста.
Существует интересная теория вторичного возникновения аденомы: первично: поражается гипоталамус, и, как следствие, происходит нарушение функции гипофиза. При воздействии рилизинг-гормонов гипоталамуса происходит повышенная стимуляция гипофиза, что приводит к избыточному росту железистых клеток, которые должны вырабатывать повышенное количество гормонов. Также существует и первичное повреждение гипофиза с образованием аденомы.
Аденомы развиваются из предшествующего очага гиперплазии[1].
Классификация
В международной классификации опухолей ЦНС (ВОЗ, 1979) сохранено разделение аденом гипофиза на основании их гистологических особенностей[1]:
- хромофобную,
- ацидофильную (эозинофильную),
- базофильную,
- смешанную ацидобазофильную и
- аденокарциному.
По мере накопления данных о несоответствии клинико-морфологических параллелей (ацидофильные — акромегалия, базофильные — гиперкортицизм, хромофобные — не обладающие гормональной активностью) возникли новые классификации. Например, по классификации С. Ю. Касумовой и соавт. (1982), выделяют гормонально-активные, гормонально-неактивные и злокачественные аденомы гипофиза[1]:
К гормонально-активным опухолям относятся:
- СТГ-секретирующая (соматотропинома),
- пролактин-секретирующая (пролактинома),
- АКТГ-секретирующая (кортикотропинома),
- ТТГ-секретирующая (тиреотропинома),
- ФСГ/ЛГ-секретирующая (гонадотропинома).
Если опухоль секретирует два и более гормона, её называют смешанная аденома.
К гормонально-неактивным относятся:
- хромофобная аденома гипофиза и
- онкоцитома.
Злокачественные аденомы встречаются крайне редко, характеризуются быстро нарастающими симптомами гипопитуитаризма, зрительными и неврологическими расстройствами[1].
Подразделение аденом проходило таким образом. Были ацидофильные, которые сопровождались повышенным производством соматотропного гормона (СТГ). Также были базофильные, продуцирующие АКТГ, хромофобные, не нарушающие синтез гормонов, и смешанные. Однако данная классификация не отвечала современным требованиям и имела много белых пятен. Поэтому в 1995 году E. Horvath и K. Kovacs предложили классификацию с учётом частоты встречаемости аденом гипофиза различных типов. Так аденомы стали подразделяться на соматотрофную, кортикотрофную, тиротрофную, маммосоматотрофную, немую, плюригормональную и др.
Посему аденомой гипофиза называется опухоль гипофиза доброкачественного течения, которая растёт из клеток передней и средней доли железы. Данное новообразование локализуется в области турецкого седла, что в клиновидной кости у основания черепа.
Аденома гипофиза включает в себя большое количество патологий, различающихся по месту расположения, клиническим проявлениям. Подобно иным опухолям аденомы различаются по способу роста, по размерам, гистологическим характеристикам, активности, выделяемых гормонов. Классификация аденом гипофиза в своём современном варианте основывается на соотношении концентрации гормонов в крови и клинической картиной. По ещё одной классификации аденомы гипофиза делят на гормонально-активные и гормонально-неактивные. Те аденомы, которые не проявляются клинически, называют гормонально-неактивными.
Классифицируют аденомы и по направленности роста. Рост определяется по отношению к турецкому седлу. На ранних этапах возникают эндоселлярные, то есть те, которые растут в полости седла. По мере роста происходит распространение опухоли ниже с достижением клиновидной пазухи, что переводит опухоль в вид инфраселлярного новообразования. При росте вверх формируется супраселлярная опухоль, кзади — ретроселлярная, в стороны — латеральная, кпереди — антеселлярная. Если опухоль растёт в нескольких направления, её название формируется из названий тех направлений, по которым наблюдается её рост. По размерам различают микроаденомы и макроаденомы.
Диагностика
МРТ является основным методом визуализации аденом гипофиза. У МРТ с КУ чувствительность достигает 90 %. Постконтрастные изображения и особенно изображения после динамического КУ являются неотъемлемой частью протокола МР-исследования гипофиза и значительно повышают диагностическую точность. Однако иногда морфологические изменения могут быть видны и на бесконстрастных изображениях. К ним относятся изменение железы со стороны аденомы, истончение и ремоделирование нижней стенки турецкого седла, а также отклонение воронки гипофиза от аденомы[2].
- на Т1 аденомы обычно изоинтенсивны по отношению к гипофизу;
- Т1-КУ:
- на динамических последовательностях — округлая область сниженного усиления по сравнению с остальной частью железы;
- на отсроченных изображениях картина варьирует от гипоусиления (наиболее распространённый вариант) до изоинтенсивности по сравнению с остальной частью железы, до гиперинтенсивности.
- Т2 — картина различная, однако в общем — небольшая гиперинтенсивность.
Очень важно помнить следующий факт при МР-исследовании гипофиза: достаточно распространены небольшие инциденталомы гипофиза, причём примерно в 2-30 % случаев при аутопсии выявляются небольшие бессимптомные микроаденомы.
Клинические проявления
Клиническая симптоматика аденом гипофиза определяется прежде всего гормональной активностью, а также размерами и направлением роста, при этом симптоматика микроаденом — только их гормональной активностью, поскольку микроаденомы не оказывают масс—эффекта. Наиболее частыми симптомами, связанными с масс-эффектом макроаденом гипофиза, являются зрительные нарушения, головные боли и гипопитуитаризм. В зависимости от направления роста опухоли может появляться симптоматика со стороны окружающих турецкое седло структур. Помимо очаговой симптоматики в клинической картине может присутствовать тревожность, усталость, апатия, бессонница и снижение памяти[3].
Лечение аденомы гипофиза
Для лечения аденомы используются различные методики, выбор которых зависит от размеров новообразования и характера гормональной активности. На сегодняшний день применяются такие подходы:
- Наблюдение. При опухолях гипофиза, которые имеют небольшие размеры и являются гормонально-неактивными, врачи выбирают выжидательную тактику. Если образование увеличивается, то назначается соответствующее лечение. Если же аденома не влияет на состояние пациента, то продолжается наблюдение.
- Медикаментозная терапия. Показана лицам с пролактиномой или соматропиномой. Назначаются препараты, блокирующие избыточную выработку гормонов, вследствие чего нормализуется гормональный фон, восстанавливается физическое и психологическое состояние пациента.
- Радиохирургическое лечение. Это современный и высокоэффективный метод лучевой терапии, основанный на разрушении опухоли радиацией, без проведения хирургических манипуляций[4].
- Операция. Хирургическое удаление аденомы гипофиза — это наиболее эффективный, но в то же время травматичный способ терапии. Специалисты владеют двумя вариантами доступа: через носовые ходы и путём вскрытия полости черепа. Первый доступ более предпочтителен, но используется только при аденомах небольшого размера.
Часто для лечения аденомы гипофиза требуется совместить несколько из этих методик для достижения необходимого результата.
Гистологическая картина
См. также
Примечания
- ↑ 1 2 3 4 5 6 Справочник по клинической эндокринологии / Под ред. Холодовой Е. А. — 1-е изд. — Минск: «Беларусь», 1998. — С. 42—48. — 510 с. — 10 000 экз. — ISBN 985-01-0031-1.
- ↑ Neuroimaging. Микроаденома гипофиза. Радиография (2018). Дата обращения: 27 марта 2019. Архивировано 27 марта 2019 года.
- ↑ Астафьева Л.И., Чернов И.В.,Чехонин И.В., Шульц Е.И.,Пронин И.Н. Аденомы гипофиза: современные принципы диагностики и лечения // Нейрохирургия : журнал. — 2020. — Т. 22(4). — С. 94–111. — doi:10.17650/1683-3295-2020-22-4-94-111.
- ↑ Безоперационное лечение аденомы гипофиза на Гамма-ноже (под редакцией нейрохирурга высшей категории, к.м.н. Иванова П.И.) (рус.). Дата обращения: 2 августа 2021. Архивировано 2 августа 2021 года.
Литература
- Аденомы гипофиза. // Алгоритмы диагностики и лечения злокачественных новообразований. Минск, 2012. С. 425—432.
- Морозова Т. А., Зборовская И. А. Аденомы гипофиза: классификация, клинические проявления, подходы к лечению и тактике ведения больных. // Лекарственный вестник, № 7, 2006. С. 19-21.
- Опухоли гипофиза: аденома, краниофарингиома, киста Ратке. Пер. с англ. Н. Д. Фирсовой (2017).